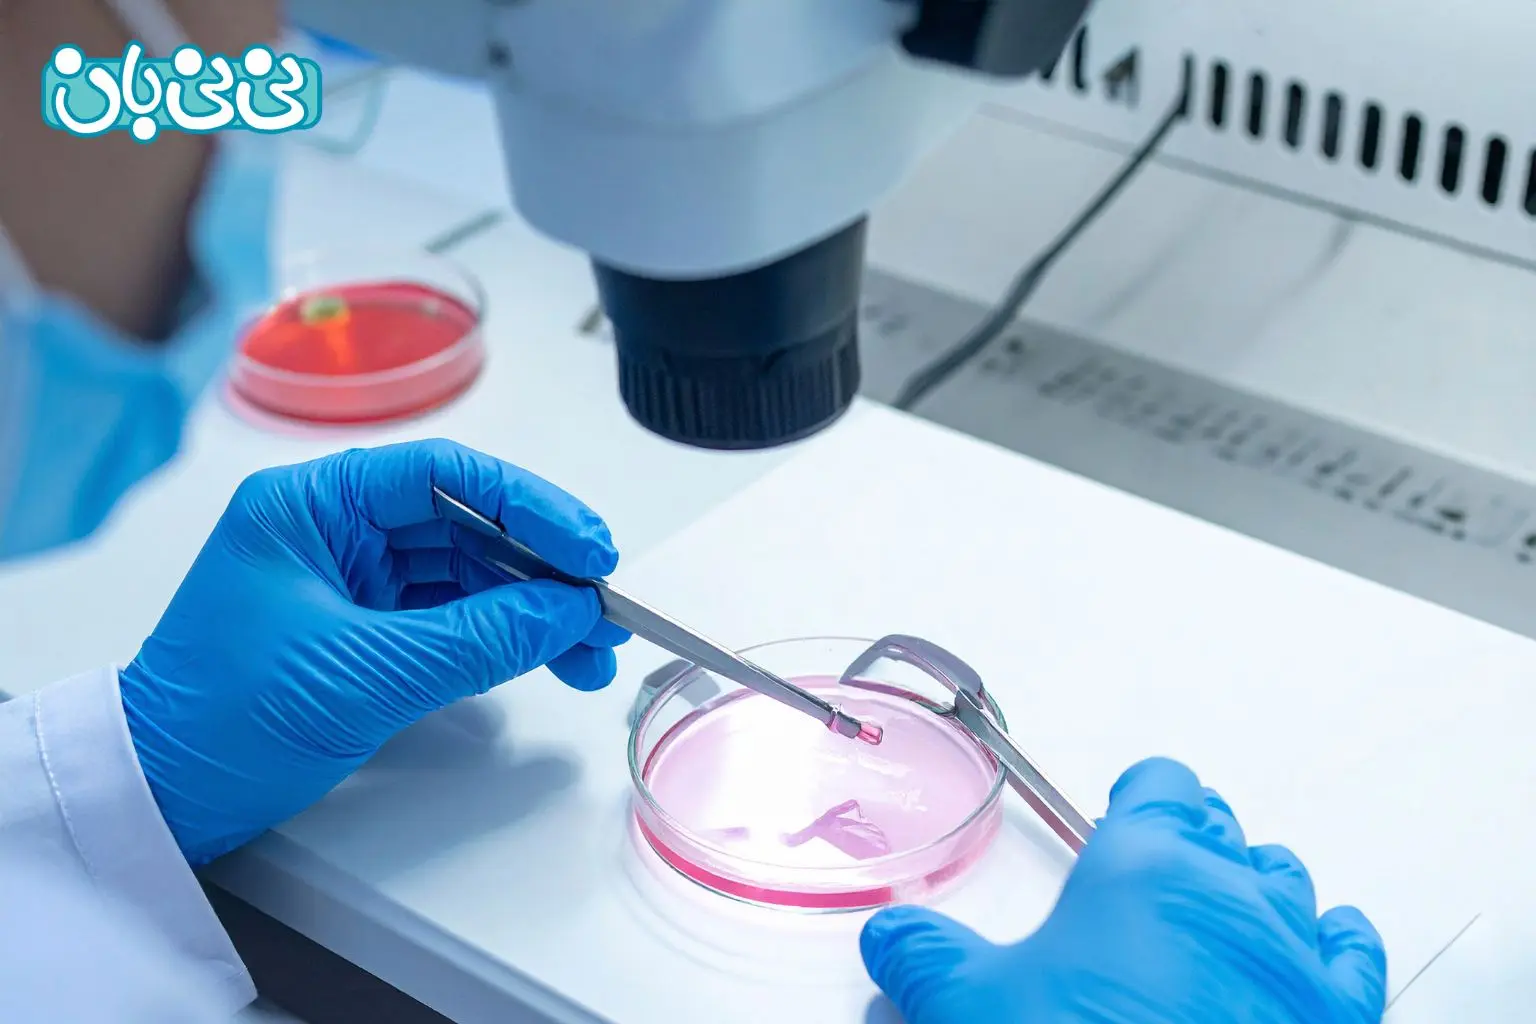
لقاح آزمایشگاهی چیست؟

از کجا بفهمم لقاح صورت گرفته است؟ ۵ مرحله لقاح
فرایند لقاح از لحظه تخمک گذاری تا لانه گزینی در رحم، معمولاً بدون علائم واضحی پیش میرود و بسیاری از زنان حتی متوجه آن نمیشوند. با این حال، شناخت دقیق مراحل لقاح، علائم اولیه احتمالی، زمانبندی مناسب برای اقدام به بارداری، عوامل بازدارنده و روشهای کمک باروری مانند IVF میتواند به زوجها کمک کند تا با آگاهی بیشتری مسیر فرزندآوری را طی کنند. در این مقاله، به تمام جنبههای علمی و عملی لقاح میپردازیم تا ابهامات رایج برطرف شود و شانس موفقیت در بارداری افزایش یابد.
فهرست مطالب
- آیا میتوان متوجه لقاح شد؟
- لقاح چگونه رخ میدهد؟
- علائم لقاح در روزهای اول چیست؟
- چند روز بعد از لقاح متوجه بارداری میشویم؟
- علائم لقاح قبل از پریود چیست؟
- علائم لقاح تخمک و اسپرم کداماند؟
- علائم لقاح موفق پسر
- علائم لقاح موفق دختر
- برای لقاح موفق چه کنیم؟
- چه عواملی مانع وقوع لقاح میشوند؟
- لقاح آزمایشگاهی چیست؟
- سوالات متداول
سوال مخاطب نینیبان: سلام و خداقوت. خانمی ۲۱ ساله هستم. یک سال است که ازدواج کردم و اقدامات ۶ ماه قبل از بارداری را انجام دادم. در حال حاضر برای بارداری اقدام کردم. میخواستم بدانم آیا وقتی اسپرم وارد بدن میشود و با تخمک لقاح پیدا میکند، علائمی دارد که ما احساس کنیم لقاح صورت گرفته است؟ با تشکر.
پاسخ دکتر آزیتا صفارزاده کرمانی، متخصص زنان و زایمان و استاد دانشگاه علوم پزشکی تهران:
هیچ علامت و نشانهای نیست که بخواهید از اینکه لقاح صورت گرفته یا نه، اطمینان حاصل کنید. فقط در تخمک گذاری است که ممکن است با احساس درد زیر شکم متوجه این مساله شوید.
آیا میتوان متوجه لقاح شد؟
یکی از سوالات رایج این است: از کجا بفهمیم لقاح صورت گرفته؟ در پاسخ باید گفت، ممکن است نشانههایی از تخمکگذاری را متوجه شوید مانند تغییرات در ترشحات دهانه رحم یا دمای پایه بدن. با این حال، بیشتر افراد لقاح را احساس نمیکنند. چند روز پس از لقاح ممکن است درد مبهم یا لکه بینی خفیف را تجربه کنید. این میتواند ناشی از لانهگزینی تخمک بارور شده در رحم باشد.
لقاح چگونه رخ میدهد؟
لقاح یا باروری زمانی اتفاق میافتد که اسپرم و تخمک به هم میپیوندند. این یکی از مراحل وقوع بارداری است.
لقاح ارتباط نزدیکی با چرخه قاعدگی زن دارد. در طول این چرخه، تخمکگذاری اتفاق میافتد؛ یعنی تخمدان یک تخمک بالغ را برای باروری آزاد میکند. ساختارهای کوچکی به نام فیمبریا به هدایت تخمک از طریق لولههای فالوپ به سمت رحم کمک میکنند. در این مسیر، تخمک میتواند توسط اسپرم بارور شود.
مردان، اسپرم را در بیضهها تولید میکنند. در زمان انزال، میلیونها اسپرم آزاد میشوند با هدف تنها یافتن و بارور کردن یک تخمک. هنگام رابطه جنسی بدون محافظت، اسپرمها از واژن بالا رفته و وارد لولههای فالوپ میشوند. میلیونها اسپرم برای رسیدن و نفوذ به تخمک رقابت میکنند اما تنها یک اسپرم، موفق به عبور از لایه بیرونی تخمک و بارور کردن آن میشود. اگر اسپرمی تخمک را بارور نکند، تخمک تجزیه میشود.
اگر اسپرم موفق به باروری شود، تخمک بارور شده (که اکنون زیگوت نامیده میشود) به حرکت خود در لوله فالوپ ادامه میدهد و به دو سلول، سپس چهار سلول و بیشتر تقسیم میشود. حدود یک هفته پس از باروری، زیگوت به رحم میرسد و اکنون خوشهای رو به رشد از حدود ۱۰۰ سلول به نام بلاستوسیست است.
بلاستوسیست سپس به دیواره رحم (آندومتر) متصل میشود. این فرایند اتصال، لانه گزینی نام دارد. با این حال، وقوع لقاح لزوماً به معنای لانه گزینی نیست. گاهی لانه گزینی رخ نمیدهد و تخمک بارور شده در پریود بعدی دفع میشود.
بیشتر بخوانید: جنین بلاستوسیت چیست؟ مراحل رشد، لانهگزینی و نقش آن در IVF
اگر لانه گزینی موفق باشد، سلولها به تقسیم ادامه میدهند و برخی به جنین و برخی دیگر به جفت تبدیل میشوند. بدن شروع به ترشح هورمونهایی میکند که خبر از رشد جنین در رحم میدهند. این هورمونها به رحم دستور میدهند که دیواره خود را حفظ کند و نریزد. به همین دلیل پریود رخ نمیدهد و این ممکن است اولین علائم بارداری باشد.
در جدول زیر مراحل لقاح بهطور خلاصه ذکر شده است.
|
مراحل لقاح |
توضیح |
|
تخمک گذاری |
تخمدان یک تخمک بالغ را آزاد میکند. ساختارهای کوچکی به نام فیمبریا به هدایت تخمک از طریق لولههای فالوپ به سمت رحم کمک میکنند. |
|
لقاح |
میلیونها اسپرم برای رسیدن به تخمک رقابت میکنند اما تنها یک اسپرم، موفق به عبور از لایه بیرونی تخمک و بارور کردن آن میشود و لقاح رخ میدهد. |
|
تقسیم سلولی |
تخمک بارور شده به حرکت خود در لوله فالوپ ادامه میدهد و به دو سلول، سپس چهار سلول و بیشتر تقسیم میشود. |
|
لانه گزینی |
تخمک بارور شده به دیواره رحم میچسبد. |
بیشتر بخوانید: علائم بارداری + ۱۰ تا از ریزترین نشانههای اولیه و قطعی حاملگی
علائم لقاح در روزهای اول چیست؟
پس از ترکیب اسپرم و تخمک، بدن زن وارد فرایندهای اولیه بارداری میشود که ممکن است علائم ظریفی ایجاد کند. این تغییرات در روزهای اول معمولاً خفیف هستند اما میتوانند نشانههای اولیهای از بارداری باشند. در ادامه، علائم لقاح در روزهای اول را ذکر میکنیم.

-
خستگی: حتی در دو روز اول پس از لقاح، بدن شروع به تولید هورمونهایی مانند پروژسترون میکند که باعث احساس خستگی در بارداری به صورت شدید و غیرمعمول میشود.
-
درد خفیف شکم: برخی زنان گرفتگی یا درد خفیفی شبیه به دردهای قبل از پریود در ناحیه پایین شکم احساس میکنند. این علامت معمولاً به دلیل حرکت تخمک بارور شده به سمت رحم و آماده سازی برای لانهگزینی است.
-
تغییر در ترشحات واژن: ترشحات واژن ممکن است افزایش یابد و غلیظتر، سفید رنگ یا کمی چسبناک شود. این تغییر به دلیل شروع تولید هورمونهای بارداری رخ میدهد.
-
حساسیت سینهها و تغییرات خلق و خو: برخی زنان افزایش حساسیت در سینهها، احساس سنگینی یا تغییرات ناگهانی در خلقوخو را تجربه میکنند که ناشی از نوسانات هورمونی اولیه است.
-
افزایش دمای بدن: دمای بدن پس از تخمک گذاری و لقاح معمولاً کمی افزایش مییابد و بالا میماند.
این علائم ترکیبی، همراه با پیگیری منظم چرخه قاعدگی و دمای بدن، میتوانند به تشخیص بهتر زمان باروری و شروع بارداری کمک کنند.
چند روز بعد از لقاح متوجه بارداری میشویم؟
زمان بروز علائم اولیه بارداری از فردی به فرد دیگر متفاوت است. برخی زنان ممکن است یک تا دو هفته پس از لقاح، حدود هفته سوم یا چهارم بارداری متوجه اولین نشانههای بارداری مانند خستگی، حساسیت سینهها یا تغییرات خفیف خلقوخو شوند. در مقابل، برخی دیگر تا پنج هفته پس از لقاح هیچ علامت واضحی احساس نمیکنند و علائم بارزتر مانند حالت تهوع یا عقب افتادن پریود در این زمان ظاهر میشود. به همین دلیل پیشنهاد میشود، حداقل یک هفته پس از عقب افتادن پریود، تست بارداری خانگی انجام دهید.
علائم لقاح قبل از پریود چیست؟
قبل از شروع پریود، بدن ممکن است علائم اولیه بارداری را نشان دهد که اغلب با علائم سندرم پیش از قاعدگی (PMS) اشتباه گرفته میشوند اما معمولاً تفاوتهایی در شدت، مدت یا زمانبندی دارند. این علائم عبارتند از:
-
درد شکم و کمر: گرفتگی یا درد خفیف تا متوسط در ناحیه پایین شکم و کمر ممکن است رخ دهد. این دردها ناشی از تغییرات هورمونی و آمادهسازی رحم برای لانهگزینی هستند و اغلب طولانیتر یا مداومتر از دردهای معمول پیش از پریود احساس میشوند.
-
حالت تهوع و تغییرات اشتها: حتی پیش از عقب افتادن پریود، برخی زنان دچار حالت تهوع صبحگاهی یا تغییر در اشتها میشوند. ممکن است نسبت به برخی غذاها یا بوها حساسیت بیشتری پیدا کنند یا میل به غذاهای خاصی افزایش یابد.
-
تاخیر در پریود: یکی از اولین و مهمترین نشانههای اولیه بارداری است. در این زمان، تخمک بارور شده در حال حرکت به سمت رحم و لانهگزینی است و سطح هورمونها مانع از ریزش دیواره رحم میشود.
علائم لقاح تخمک و اسپرم کداماند؟
لقاح زمانی رخ میدهد که اسپرم با موفقیت به تخمک رسیده و هستههای آنها ترکیب شود. این فرایند معمولاً در لولههای فالوپ اتفاق میافتد و علائم واضحی ندارد اما بدن بلافاصله شروع به واکنش هورمونی میکند. اولین نشانههای غیرمستقیم لقاح شامل افزایش ناگهانی پروژسترون، تغییرات ظریف در ترشحات واژینال (شفاف، کشدار یا غلیظتر شدن)، احساس خستگی زودرس، حساسیت خفیف در سینهها و گاهی گرفتگی ملایم در پایین شکم است که ممکن است با علائم تخمک گذاری یا پیش از پریود اشتباه گرفته شود. با این حال، این علائم قطعی نیستند و تنها با تست بارداری یا آزمایش خون hCG قابل تایید خواهند بود.
علائم لقاح موفق پسر
از نظر علمی، علائم خاصی برای لقاح پسر یا دختر وجود ندارد اما برخی معتقدند که علائم لقاح موفق پسر به شرح زیر است:
- خلق و خوی بهتر: زنانی که پسر باردار هستند، ممکن است خلقوخوی بهتر و هیجان بیشتری داشته باشند.
- ترشحات واژنی کمتر: در باورهای عامیانه گفته میشود که در بارداری پسر، ترشحات واژینال معمولاً کمتر از بارداری دختر است.
- افزایش انرژی و نشاط: برخی زنان گزارش میدهند که در اوایل بارداری پسر، احساس انرژی و نشاط بیشتری دارند.
علائم لقاح موفق دختر
همانطور که پیشتر اشاره کردیم از نظر علمی نمیتوان علائم خاصی برای جنسیت جنین در زمان لقاح برشمرد. با این وجود، برخی افراد گمان میکنند که علائم لقاح موفق دختر شامل حالت تهوع شدیدتر، افزایش ترشحات واژن در بارداری و حساسیت بیشتر به بوها میشود.
برای لقاح موفق چه کنیم؟
لقاح موفق نیازمند برنامهریزی دقیق، سبک زندگی سالم و زمانبندی مناسب است. بارداری معمولاً در یک دوره ۲ تا ۶ ماهه تلاش منظم رخ میدهد. اقدامات اصلی برای افزایش شانس لقاح موفق عبارتند از:
- داشتن رابطه جنسی منظم: حداقل هر ۲ تا ۳ روز یک بار، بهویژه بلافاصله پس از پایان پریود و در پنجره باروری (۵ تا ۶ روز قبل از تخمکگذاری تا ۱ تا ۲ روز پس از آن) رابطه داشته باشید.
- شناسایی دقیق زمان تخمک گذاری: با پیگیری علائم تخمک گذاری (مانند تغییرات ترشحات واژینال شفاف و کشدار یا افزایش دمای پایه بدن) پنجره باروری را مشخص کنید و در این بازه، رابطه جنسی را متمرکز کنید.
- حفظ وزن ایدهآل: اضافه وزن یا کمبود وزن میتواند باعث اختلال در تخمکگذاری شود. حفظ شاخص توده بدنی (BMI) در محدوده طبیعی (۱۸.۵ تا ۲۴.۹) به تنظیم هورمونها و افزایش شانس لقاح کمک میکند.
- مشورت با متخصص زنان: قبل از اقدام به بارداری، با پزشک مشورت کنید تا سلامت کلی، وضعیت تخمدانها، هورمونها و سابقه پزشکی بررسی شود. پزشک ممکن است آزمایشهای لازم یا مکملهای اضافی مانند ویتامین D یا آهن را توصیه کند.
- اجتناب از عوامل مضر: سیگار، الکل، کافئین بیش از حد و استرس را کاهش دهید و از قرار گرفتن در معرض مواد شیمیایی سمی خودداری کنید.
با رعایت این اقدامات و پیگیری منظم، شانس لقاح موفق در چند ماه اول به طور قابل توجهی افزایش مییابد.
چه عواملی مانع وقوع لقاح میشوند؟
برخی بیماریها و شرایط سلامتی ممکن است توانایی باردار شدن شما را تحت تاثیر قرار دهند. حتی اگر اسپرم و تخمک با هم برخورد کنند، لزوماً لقاح رخ نمیدهد. شایعترین عوامل عبارتند از:
- عدم تخمک گذاری
- تعداد کم اسپرم یا مشکلات حرکتی اسپرم
- انسداد در بیضهها، تخمدانها یا لولههای فالوپ
- کاهش تعداد و کیفیت تخمکها و اسپرمها (معمولاً مرتبط با افزایش سن)
لقاح آزمایشگاهی چیست؟
لقاح آزمایشگاهی (IVF) به معنای پیوند تخمک زن و اسپرم مرد در یک ظرف آزمایشگاهی است. بهطور معمول، تخمک داخل بدن زن بارور میشود. اگر تخمک بارور شده به دیواره رحم بچسبد و رشد کند، حدود ۹ ماه بعد نوزاد به دنیا میآید. این فرایند لقاح طبیعی نام دارد. در مقابل IVF از تکنیکهای پزشکی ویژه برای کمک به بارداری زن استفاده میشود. در ادامه، 5 مرحله اصلی آی وی اف را توضیح میدهیم.
بیشتر بخوانید: درمان ناباروری با آی وی اف، تمام آنچه که باید بدانید
مرحله اول: تحریک یا سوپر اوولاسیون
- به زن داروهای باروری تزریق میشود تا تولید تخمک افزایش یابد.
- بهطور طبیعی، زن هر ماه یک تخمک تولید میکند. داروها به تخمدانها دستور میدهند چند تخمک تولید کنند.
- در این مرحله، بهطور منظم سونوگرافی ترانس واژینال برای بررسی تخمدانها و آزمایش خون برای کنترل سطح هورمونها انجام میشود.
مرحله دوم: برداشت تخمک
- یک عمل جراحی کوچک به نام آسپیراسیون فولیکول برای خارج کردن تخمکها از بدن زن انجام میشود.
- این عمل معمولاً در مطب پزشک انجام میشود. به زن داروهای بیحسی داده میشود تا دردی احساس نکند.
- پزشک با راهنمایی تصویر سونوگرافی، یک سوزن نازک را از واژن به داخل تخمدان و کیسههای حاوی تخمک (فولیکولها) وارد میکند. سوزن به دستگاه مکش متصل است و تخمک و مایع را یکی یکی خارج میکند.
- این کار برای تخمدان دیگر هم تکرار میشود. ممکن است پس از عمل، کمی گرفتگی عضلانی وجود داشته باشد که ظرف یک روز برطرف میشود.
- در موارد نادر، ممکن است از لاپاراسکوپی لگنی برای برداشت تخمک استفاده شود. اگر زن تخمک تولید نکند یا نتواند، از تخمک اهدایی استفاده میشود.
مرحله سوم: تلقیح و لقاح
- اسپرم مرد با بهترین تخمکها مخلوط میشود. این مخلوط کردن تلقیح نام دارد.
- تخمک و اسپرم در محفظه کنترل شده محیطی نگهداری میشوند. معمولاً چند ساعت پس از تلقیح، اسپرم وارد تخمک میشود.
- اگر احتمال لقاح کم باشد، اسپرم مستقیماً به داخل تخمک تزریق میشود. بسیاری از مراکز بهطور روتین اسپرم را به داخل تخمک تزریق میکنند، حتی اگر همه چیز طبیعی به نظر برسد.
مرحله چهارم: کشت جنین
- وقتی تخمک بارور شده تقسیم شود، جنین نام میگیرد. کارکنان آزمایشگاه بهطور منظم جنین را بررسی میکنند تا از رشد صحیح آن مطمئن شوند.
- ظرف حدود ۵ روز، یک جنین طبیعی چندین سلول در حال تقسیم دارد.
- زوجهایی که خطر انتقال بیماری ژنتیکی به فرزند دارند، میتوانند تشخیص ژنتیکی پیش از لانهگزینی (PGD) انجام دهند. این کار معمولاً ۳ تا ۵ روز پس از لقاح انجام میشود. یک یا چند سلول از هر جنین برداشته شده و برای بیماریهای ژنتیکی خاص غربالگری میشود.
- PGD به والدین کمک میکند تصمیم بگیرند کدام جنین را منتقل کنند و خطر انتقال بیماری به فرزند را کاهش میدهد. این روش بحثبرانگیز است و در همه مراکز ارائه نمیشود.
مرحله پنجم: انتقال جنین
- جنینها ۳ تا ۵ روز پس از برداشت تخمک و لقاح به رحم زن منتقل میشوند.
- این عمل در مطب پزشک و در حالت بیداری زن انجام میشود. پزشک یک لوله نازک (کاتتر) حاوی جنین را از واژن، از طریق دهانه رحم به داخل رحم وارد میکند.
- اگر جنین به دیواره رحم بچسبد و رشد کند، بارداری رخ میدهد.
- ممکن است بیش از یک جنین همزمان منتقل شود که میتواند منجر به دوقلو، سه قلو یا بیشتر شود. تعداد دقیق جنین منتقل شده به عوامل زیادی بستگی دارد، بهویژه سن زن.
- جنینهای استفاده نشده میتوانند فریز شده و در آینده منتقل یا اهدا شوند.
نقل قول از:
A woman taking fertility medicines may have bloating, abdominal pain, mood swings, headaches, and other side effects. Repeated IVF injections can cause bruising.
ترجمه:
زنی که داروهای باروری مصرف میکند ممکن است دچار نفخ، درد شکمی، نوسانات خلقی، سردرد و سایر عوارض جانبی شود. تزریقهای مکرر IVF نیز میتواند باعث کبودی شود.
سخن پایانی
در نهایت، علائم اولیه لقاح زودهنگام مانند خستگی، حساسیت سینهها یا لکهبینی میتوانند سرنخهایی باشند اما تنها تست بارداری یا آزمایش خون قابل اعتماد است. با برنامهریزی دقیق زمان رابطه، حفظ سلامت جسمی و روانی، دوری از عوامل مضر و در صورت نیاز استفاده از روشهای کمک باروری مانند آی وی اف، میتوانید شانس لقاح موفق را به حداکثر برسانید.